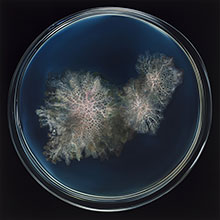

Anna Camners sparsmakade och intrikata måleri exponeras den här gången mot mörkt roströda väggar i Galerie Forsbloms inre rum. Målningarna med sina händelser mot svart botten kommer förvånansvärt väl till sin rätt. Ackordet svart, vitt mot rött är nedärvt, symboliskt eggande (blod, död och aska) och nutidshistoriskt skrämmande.
I Anna Camners tappning möter man objekt som skulle kunna vara hämtade från ett övergivet behandlingsrum eller laboratorium. Svagt rosaskiftande och vitaktiga ämnen ser ut som kasserade löständer under produktion och vilar som sockerbitar i sin rektangulära bur, fångade av pannåns ytterkanter. Vaxartade ämnen ler som lösgommar mot betraktaren, eller från vilket imiterande, kroppsnära område de än är hämtade från. Silkeduken märkt av användning eller ålder hänger mot sin svarta grund.
Med sin minutiösa penselföring och färgbehandling har Camner sedan länge inmutat sitt eget revir av egendomligheter. Som bäst blir det när målarhändelserna får någon form av organisk koppling eller antydd figuration.
 |
| © Anna Camner (Klicka på bilden för hög upplösning) |
Redan utställningens titel väcker viss nyfikenhet som stillas av att den ingår i en sångtext av David Bowie, men den leder också vidare ut till obskyrare områden på nätet: A plague I Call a Hearbeat. Min första association går dock till barndomsupplevelsen när man ska sova och hjärtslagen i örat mot kudden obehagligt påminner om själva levandet, som kroppen normalt sköter oss förutan. Fixerade man sig vid dem var det stört omöjligt att somna.
Och frågan är om inte Camners märkliga världar påminner på ett liknande vis om livspulsens princip, elan vital, för att travestera filosofen Henri Bergson. Men här befinner sig hjärtslagen på gränsen till sitt upphörande, eller så har de strax innan stannat och nedbrytandets vitaliserande processer tagit vid. Påsarna med sockerlösning eller kontrastvätska ligger kvar oanvända.
Det är spännande att följa Camner som tar sig friheten att utvecklas långsamt men metodiskt, framåtriktat. I de mer abstrakt verkande bilderna söker hon sig vidare och det skall bli intressant att se om de leder mot en återvändsgränd, eller om de öppnar nya världar att hemsökas av.
Stockholm 2019-10-19 © Susanna Slöör |
© Anna Camner

© Anna Camner

© Anna Camner
(Klicka på bilden för hög upplösning)
Foto: Jean-Baptiste Béranger / Galerie Forsblom |